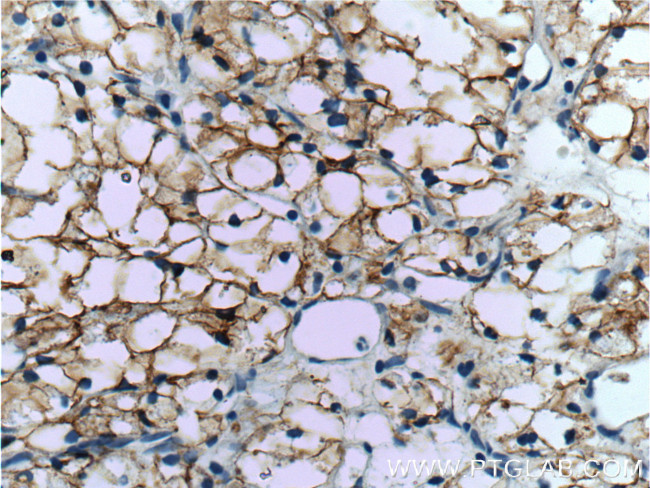
CA9 Antibody in Immunohistochemistry (Paraffin) (IHC (P))
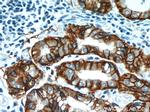
CA9 Antibody in Immunohistochemistry (Paraffin) (IHC (P))

Search
Proteintech
CA9 Polyclonal Antibody
{{$productOrderCtrl.translations['antibody.pdp.commerceCard.promotion.promotions']}}
{{$productOrderCtrl.translations['antibody.pdp.commerceCard.promotion.viewpromo']}}
{{$productOrderCtrl.translations['antibody.pdp.commerceCard.promotion.promocode']}}: {{promo.promoCode}} {{promo.promoTitle}} {{promo.promoDescription}}. {{$productOrderCtrl.translations['antibody.pdp.commerceCard.promotion.learnmore']}}
产品信息
11071-1-AP
种属反应
已发表种属
宿主/亚型
分类
类型
抗原
偶联物
形式
浓度
规格
纯化类型
保存液
内含物
保存条件
运输条件
产品详细信息
Immunogen sequence: LLMPVHPQR LPRMQEDSPL GGGSSGEDDP LGEEDLPSEE DSPREEDPPG EEDLPGEEDL PGEEDLPEVK PKSEEEGSLK LEDLPTVEAP GDPQEPQNNA HRDKEGDDQS HWRYGGDPPW PRVSPACAGR FQSPVDIRPQ LAAFCPALRP LELLGFQLPP LPELRLRNNG HSVQLTLPPG LEMALGPGRE YRALQLHLHW GAAGRPGSEH TVEGHRFPAE IHVVHLSTAF ARVDEALGRP GGLAVLAAFL EEGPEENSAY EQLLSRLEEI AEEGSETQVP GLDISALLPS DFSRYFQYEG SLTTPPCAQG VIWTVFNQTV MLSAKQLHTL SDTLWGPGDS RLQLNFRATQ PLNGRVIEAS FPAGVDSSPR AAEPVQLNS (31-408 aa encoded by BC014950)
靶标信息
Carbonic anhydrase (CA) is an enzyme that assists rapid interconversion of carbon dioxide and water into carbonic acid, protons, and bicarbonate ions. It is abundant in all mammalian tissues. There are many genes that are inducible by hypoxia, via HIF-1 alpha. CA IX is one of the most inducible genes because of its stability and location within the membrane. Carbonic anhydrases have a widespread role in regulating pH in normal tissues, by regulating hydrogen ion (H+) flux. The pH is important in cell death under hypoxia, thus a blockade of CA IX results in increased cell death under hypoxia. Therefore, CA IX has become a reliable histochemical marker of hypoxia.
仅用于科研。不用于诊断过程。未经明确授权不得转售。
生物信息学
蛋白别名: CA IX variant; CA-9; CA-IX; Carbonate dehydratase IX; Carbonic anhydrase 9; Carbonic anhydrase IX; carbonic dehydratase; Membrane antigen MN; Membrane antigen MN homolog; P54 / 58N; P54/58N; pMW1; RCC-associated antigen G250; RCC-associated protein G250; Renal cell carcinoma-associated antigen G250
基因别名: CA9; CAIX; Car9; G250; MN; MN/CA9
UniProt ID: (Human) Q16790, (Mouse) Q8VHB5
Entrez Gene ID: (Human) 768, (Mouse) 230099, (Rat) 313495